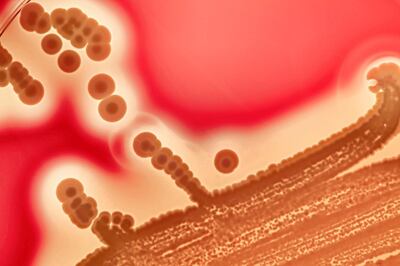
Antibiotic overuse poses a genuine threat today. Getty

We all know we’re fighting a losing battle against deadly infections, as microbes become resistant to ever more antibiotics. And we all know how to do our bit to avoid defeat: only take antibiotics prescribed by a doctor – and finish the whole course.
As medical advice, it’s simple, clear and makes sense. After all, it’s vital to kill all the bugs, lest they find ways of evading the treatment.
But now a major row has broken out among health experts following a study claiming the textbook advice is flat wrong.
According to the study, published by UK researchers in the British Medical Journal, there’s no evidence that finishing the full course of antibiotics really does combat resistance.
Its authors argue it may even make the problem worse, by giving bacteria more exposure to the antibiotic, and thus more opportunity to find ways to beat it.
So what we should be doing, they say, is to stop taking antibiotics as soon as we feel better.
Such advice was always going to cause trouble. Ever since the introduction of antibiotics in the 1940s, the focus has been on making sure the dose is given long enough to stop the infection.
The first patient ever treated with penicillin died a month after a seemingly amazing recovery because his doctors simply ran out of the newly discovered wonder-drug, and his infection came roaring back.
Understandably, the idea of letting patients stop simply when they feel better has sparked alarm among health experts.
They have rushed to slap down the authors of the BMJ paper. In the UK, the Royal College of General Practitioners said it could not advocate a change in practice on the basis of just one study.
In the US, an expert on antibiotic resistance at the Centers for Disease Control warned that feeling better is not a good enough reason for stopping a course of treatment early without medical advice.
But as the BMJ paper makes clear, there is evidence that taking antibiotics for too long can cause harm.
As well as giving bad microbes more exposure to antibiotics, our bodies contain a host of “good” microbes that play a key role in protecting our health and well-being. Antibiotics can devastate these, and in the process create less Darwinian competition for nastier bacteria.
The upshot is clear: there must be a “sweet spot” for the duration of a course of antibiotics.
Critics of “stop when you feel better” have claimed it’s best to finish the prescribed course because your doctor will have tailored it to suit you best.
It’s a comforting argument but it glosses over an awkward fact: no one knows how to do this.
As ever, experts on both sides of the argument are calling for more research. That means setting up so-called randomised controlled trials (RCTs), the “gold standard” for finding out the best form of treatment.
These trials randomly assign patients to groups, each of which receives the various treatment options, and then compare how they fare. The random selection means all the groups are equally likely to get their share of patients with quirks leading to atypical responses. When the final results are compared, these cancel each other out, revealing how the average patient will respond.
The problem is, when it comes to antibiotic treatment of infection, the average patient doesn’t exist.
There’s a host of variables that can influence how we respond to both the infection and its treatment, from the state of our immune system to organ problems that alter our response to drugs.
In theory, these can all be accounted for but the resulting RCTs would have to be huge – and hugely expensive. As drugs companies have little interest in funding anything but trials of new treatments, it’s not clear who would pay for these mega-trials.
And so the circle of ignorance remains unbroken, while the microbes continue to evolve new ways of beating our best defences.
In the absence of any hard evidence, what should we make of this latest medical controversy?
For now, the consensus appears to be that we should ignore the advice to “stop when you feel better”. While it may well help slow antibiotic resistance, that remains a much broader, long-term concern – and one being tackled in other ways, such as clamping down on cavalier prescribing.
In contrast, the old advice to “finish the course” may well do little to stop antibiotic resistance - but it does carry a lower risk of being fooled into thinking we’re cured when we’re not.
Medical scientists may be fighting a global war against a relentless enemy but doctors should still focus on curing the patient in front of them.
Robert Matthews is Visiting Professor of Science at Aston University, Birmingham, UK